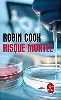
livre risque mortel

Livre Risque mortel

Tous nos livres sont soigneusement vérifiés par nos acheteurs.
Offre disponible
Options de livraison pour ce produit
- Retrait magasin - Gratuit sous 48h
- La poste - standard - Sous 4 jours ouvrés*
- La poste - colissimo - Sous 4 jours ouvrés*
- Point de retrait - Sous 4 jours ouvrés*
* En France métropolitaine.
Informations sur l'offre sélectionnée
| Titre complet | Livre Risque mortel |
| État d'article | Bon état |
| Actuellement à | Coignières |
| Code | 869662 |
| Référence | 290866 |
| Date de sortie | 7 octobre 1998 |
| Code EAN | 9782253170457 |
| Format | Poche † |
| Nombre de page(s) | 444 |
| Genre | Thrillers ; Romans policiers |
| Auteur | Robin Cook |
| Editeur | Le Livre de Poche |
| Langue | Français |